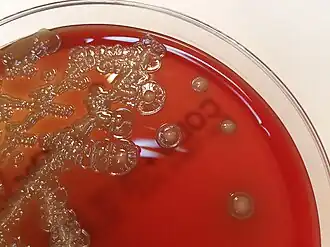
Description de cette image, également commentée ci-après

Flavobacteriia
Flavobacteriia
Bergeyella zoohelcum, une espèce de la classe Flavobacteriia
| Domaine | Bacteria |
|---|---|
| Phylum | Bacteroidota |
Les Flavobacteriia sont une classe de bactéries comprenant les Flavobacteriaceae.
Description
Liste des ordres
- Flavobacteriales Bernardet 2012
- Bactéries non encore assignées à un ordre : comprend des bactéries n'appartenant pas à l'ordre Flavobactériales mais figurant parmi les Flavobacteriia
Taxonomie
Le nom correct complet (avec auteur) de ce taxon est Flavobacteriia Bernardet 2012[1].
Le genre type est : Flavobacterium Bergey et al. 1923[1].
Étymologie
L'étymologie du nom de cette classe est la suivante : N.L. neut. n. Flavobacterium,genre type de l'ordre type de cette classe; N.L. neut. pl. n. Flavobacteriia, la classe de l'ordre Flavobacteriales[1].
Références
Bibliographie
- Publication originale (en) Jean-François Bernardet, « Class II. Flavobacteriia class. nov. », dans Krieg NR, Staley JT, Brown DR, Hedlund BP, Paster BJ, Ward NL, Ludwig W, Whitman WB (eds), Bergey's Manual of Systematic Bacteriology, vol. 4, New York, Springer, , 2e éd., p. 105
Liens externes
- (en) Catalogue of Life : Flavobacteriia Bernardet, 2012 (consulté le )
- (fr + en) GBIF : Flavobacteriia Non Valide (consulté le ) La base GBIF n'est pas à jour des données LPSN
- (en) IRMNG : Flavobacteriia (consulté le )
- (fr + en) ITIS : Flavobacteriia Bernardet, 2012 (consulté le )
- (en) LPSN : Flavobacteriia Bernardet 2012 (consulté le )
- (en) NCBI : Flavobacteriia (taxons inclus) (consulté le )
- (en) Taxonomicon : Flavobacteriia Bernardet 2012 (consulté le )
- Portail de la microbiologie